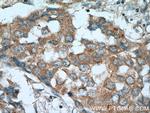
RARA Antibody in Immunohistochemistry (Paraffin) (IHC (P))
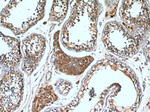
RARA Antibody in Immunohistochemistry (Paraffin) (IHC (P))

Search
Proteintech
RARA Polyclonal Antibody
{{$productOrderCtrl.translations['antibody.pdp.commerceCard.promotion.promotions']}}
{{$productOrderCtrl.translations['antibody.pdp.commerceCard.promotion.viewpromo']}}
{{$productOrderCtrl.translations['antibody.pdp.commerceCard.promotion.promocode']}}: {{promo.promoCode}} {{promo.promoTitle}} {{promo.promoDescription}}. {{$productOrderCtrl.translations['antibody.pdp.commerceCard.promotion.learnmore']}}
产品信息
10331-1-AP
种属反应
宿主/亚型
分类
类型
抗原
偶联物
形式
浓度
规格
纯化类型
保存液
内含物
保存条件
运输条件
产品详细信息
Immunogen sequence: RIYKPCFVC QDKSSGYHYG VSACEGCKGF FRRSIQKNMV YTCHRDKNCI INKVTRNRCQ YCRLQKCFEV GMSKESVRND RNKKKKEVPK PECSESYTLT PEVGELIEKV RKAHQETFPA LCQLGKYTTN NSSEQRVSLD IDLWDKFSEL STKCIIKTVE FAKQLPGFTT LTIADQITLL KAACLDILIL RICTRYTPEQ DTMTFSDGLT LNRTQMHNAG FGPLTDLVFA FANQLLPLEM DDAETGLLSA ICLICGDRQD LEQPDRVDML QEPLLEALKV YVRKRRPSRP HMFPKMLMKI TDLRSISAKG AERVITLKME IPGSMPPLIQ EMLENSEGLD TLS (83-424 aa encoded by BC008727)
靶标信息
RARA is a receptor for retinoic acid. Retinoic acid receptors bind as heterodimers to their target response elements in response to their ligands, all-trans or 9-cis retinoic acid, and regulate gene expression in various biological processes. The RXR/RAR heterodimers bind to the retinoic acid response elements (RARE) composed of tandem 5'-AGGTCA-3' sites known as DR1-DR5. In the absence of ligand, the RXR-RAR heterodimers associate with a multiprotein complex containing transcription corepressors that induce histone acetylation, chromatin condensation and transcriptional suppression. On ligand binding, the corepressors dissociate from the receptors and associate with the coactivators leading to transcriptional activation. RARA plays an essential role in the regulation of retinoic acid-induced germ cell development during spermatogenesis. Has a role in the survival of early spermatocytes at the beginning prophase of meiosis. In Sertoli cells, may promote the survival and development of early meiotic prophase spermatocytes. In concert with RARG, required for skeletal growth, matrix homeostasis and growth plate function. Regulates expression of target genes in a ligand-dependent manner by recruiting chromatin complexes containing KMT2E/MLL5. Mediates retinoic acid-induced granulopoiesis.
仅用于科研。不用于诊断过程。未经明确授权不得转售。
生物信息学
蛋白别名: nuclear receptor; Nuclear receptor subfamily 1 group B member 1; nucleophosmin-retinoic acid receptor alpha fusion protein NPM-RAR long form; PML gene product; PML-DDX5-RARA fusion; PML-DDX5-RARA fusion protein; RAR Alpha; RAR alpha 1; RAR-alpha; RARA; retinoic acid; retinoic acid receptor; Retinoic acid receptor alpha; retinoic acid receptor, alpha polypeptide; RRA; TTMV/RARA fusion; TTMV/RARA fusion protein; unnamed protein product
基因别名: NR1B1; RAR; RARA; RARalpha; RARalpha1
UniProt ID: (Human) P10276, (Mouse) P11416
Entrez Gene ID: (Human) 5914, (Rat) 24705, (Mouse) 19401